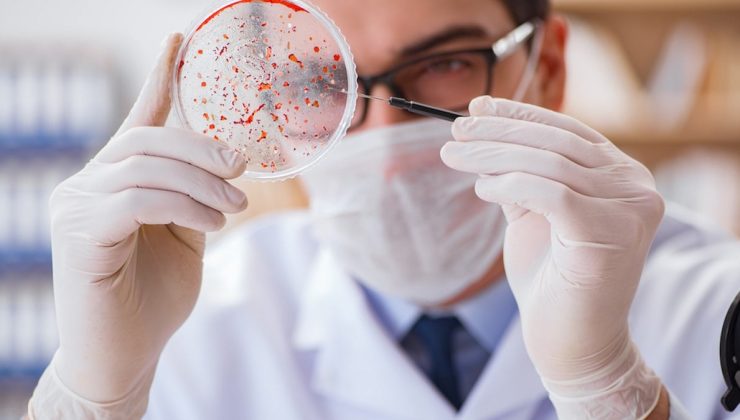
30 yıl sonra yeniden hortladı, Avrupa alarma geçti: Veba laboratuardan mı yayıldı?

30 yıl sonra yeniden hortladı, Avrupa alarma geçti: Veba laboratuardan mı yayıldı?
İspanya yetkilileri, ülkede hızla yayılan domuz vebasına karşı alarma geçti. Veba, yetkililer tarafından merceğe alındı.
Vebanın nereden çıktığı ve nasıl engellenebileceğini araştıran yetkililer, endişe verici bir olasılığı ortaya çıkardı: Ülkede hızla yayılan veba, laboratuardan sızmış olabilir.

Barcelona yakınlarında beş laboratuvar olası kaynak olarak inceleniyor. 13 yaban domuzunda hastalık doğrulandı. Yetkililer, kaynağı bularak yayılmanın önüne geçmek için çalışmaları hızlandırdı.
O BULGU ENDİŞELERİ ARTTIRDI
İlk değerlendirmede virüsün dışarıdan gelen kirli bir gıdayı yiyen bir yabani domuzla yayılmaya başlamış olabileceği düşünülmüştü. Olası senaryolardan biri yola atılmış bir etli sandviçti.
Tarım Bakanlığı yeni bir bulguya dayanarak yön değiştirdi. Ölü domuzlarda bulunan virüs suşunun AB ülkelerinde dolaşan suşla (virüs örneği) aynı olmadığı saptandı.
Buna göre virüs 2007’de Gürcistan’da görülen türe benziyor. Bakanlık bu benzerliğin biyolojik güvenlik tesisinden sızıntı ihtimalini dışlamadığını belirtti.
Gürcistan 2007 suşu, deneylerde ve aşı çalışmalarında sık kullanılan bir referans virüs olarak biliniyor. Bu sebeple vebanın laboratuardan yayıldığı olasılığı daha da güçleniyor.
ORDU GÖREVE ÇAĞRILDI
Orduya bağlı acil durum ekiplerinden yüzü aşkın personelle, polis ve korucularla birlikte sahaya gönderildi.
Bölge yönetimi hiçbir ihtimali elemediğini ve önce ne olduğunu anlamak istediklerini duyurdu. İlk odağa 6 kilometre içinde bulunan 37 yabani hayvanın daha incelendiği ve hepsinin negatif çıktığı açıklandı.
Katalonya Bölgesel Başkanı Salvador Illa salgın alanına 20 kilometre mesafedeki beş tesiste denetim emri verdi. Çevredeki 39 domuz çiftliğinde hastalık izine rastlanmadı.
Ülkenin domuz eti ihracatı yılda 8.8 milyar euro değerinde. Eğer veba yayılırsa, ülkenin ekonomisi büyük bir darbe alırken halk sağlığı tehlikeye girecek.
Virüs insanlara zarar vermiyor fakat domuzlarda çoğu zaman ölümcül seyrediyor. İspanya AB’nin en büyük domuz eti üreticisi ve geçen yıl hem AB içi hem de dış pazarlara milyarlarca Euro’luk ihracat yaptı.
